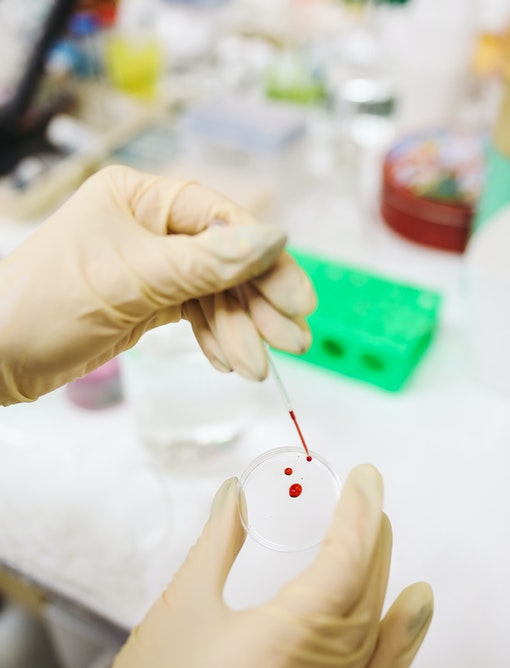

Our Services
Patient care and safety is paramount to us
Laproscopic Surgery
Our Surgeons are highly skilled in Laproscopy, a
minimally invasive surgery. It allows for shorter hospital stays, faster
recovery, less pain, and smaller scars than traditional (open) surgery.
Trauma & Emergency
Our 15 bedded ICU is designed for those patients
requiring continuous observation and care. The department is supported by an
efficient team of highly trained paramedical staff and nurses.
Neuro Surgery
We have an excellent team of doctors specialized in
neurology and neurosurgery. We provide comprehensive treatment for a broad range
of conditions like Backache, Spinal disorders, etc.
Onco Surgery
Our team of surgical oncologists are well experienced and
have worked in advanced cancer centers. They know the latest advancements in
surgical techniques and medicines.
Liver & Pancreatic Surgery
At Manur Hospital, We have the best in class
infrastructure and well trained team of specialists to diagnose, treat & prevent
all forms of liver and pancreatic disorders.
Gynaecology
Our team of gynecologists offer a wide variety of
treatments and services specifically designed to meet women’s health and
wellness needs during every stage of their lives.
Medical Lab
Our integrated Medical Diagnostics Laboratory has all the
major tests and allows us for a faster evidence based treatment.
Pharmacy
We have a 24 / 7 in-house pharmacy for all the
pharmaceutical and wellness needs where the stocks are adequately maintained.
Ambulance Service
Our Ambulance fitted with GPS is one of the fastest in
the city. We are only a call away for an immediate response to your medical
need.
Register yourself for Consultation with one of our professional Doctors.
Our Specialties
Truly Multi-Speciality
Latest
News, Blogs & Events